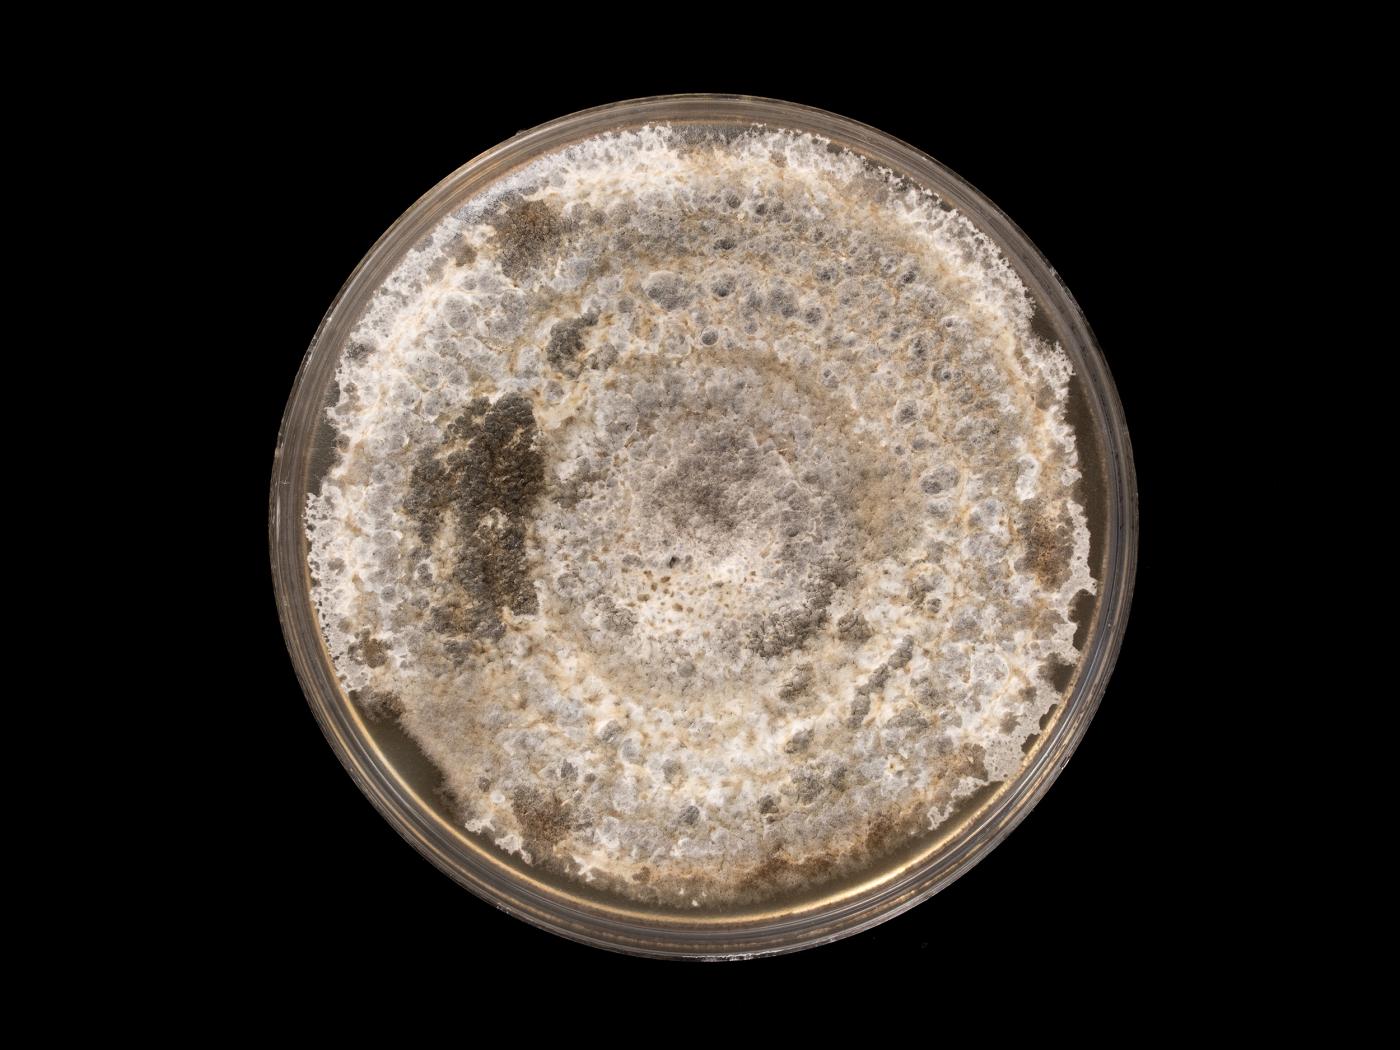

- Conidies : Conidies ovoïdes à obpyriformes (= en forme de poire inversée). Dictyospores (3-8 septations transversales et 1-2 septations longitudinales). Avec un court rustrum. D'une teinte vert olive à brune. Paroi parfois échinulée. Les conidies forment de longues chaînes acropétales (= la plus jeune conidie étant à l’apex de la chaîne) de 15-20 conidies. Dimension très variable : 10-43 x 5-14 µm.
- Conidiophores : Bruns. Généralement simples mais parfois ramifiés. Droits et septés. Dimension : 40-70 x 3-4 µm.
Alternaria alternata et Alternaria mali produisent des conidies qui se ressemblent.
Le champignon Alternaria alternata peut affecter les cultures suivantes : ail, aneth, aubergine, avoine, bette à carde, betterave potagère, betterave sucrière, blé d'automne, blé de printemps, bleuet en corymbe, bleuet nain, brocoli, camerise, canola, carotte, carvi, cerise, cerise de terre, chou pommé, chou-fleur, ciboulette, citrouille, colza, concombre, coriandre, courges, cytise, ginseng d'amérique, ginseng à cinq folioles, glaïeuls, hostas, laitue (feuille), laitue (pommée), laitues, lilas, maïs grain et fourrager, maïs sucré, melons (cantaloup, melon miel, etc.), orge, persil, pins, poire, pois de jardin, pois protéagineux, poivron, pomme, pomme de terre, rhubarbe, orpin/sédum, seigle d'automne, soya, tabacs d'ornement, tournesols et triticale
Cultures ou autres organismes affectés
Aubergine

Bette à carde
 Bette à carde - Alternariose (Alternaria alternata)_2
Bette à carde - Alternariose (Alternaria alternata)_2
 Bette à carde - Alternariose (Alternaria alternata)_3
Bette à carde - Alternariose (Alternaria alternata)_3
 Bette à carde - Alternariose (Alternaria alternata)_4
Bette à carde - Alternariose (Alternaria alternata)_4
 Bette à carde - Alternariose (Alternaria alternata)_5
Bette à carde - Alternariose (Alternaria alternata)_5

Cerise de terre
 Cerise de terre - Alternariose du fruit (Alternaria alternata)_2
Cerise de terre - Alternariose du fruit (Alternaria alternata)_2
 Cerise de terre - Alternariose du fruit (Alternaria alternata)_3
Cerise de terre - Alternariose du fruit (Alternaria alternata)_3
 Cerise de terre - Alternariose du fruit (Alternaria alternata)_4
Cerise de terre - Alternariose du fruit (Alternaria alternata)_4

Cerise de terre
 Cerise de terre - Alternariose (Alternaria alternata)_2
Cerise de terre - Alternariose (Alternaria alternata)_2
 Cerise de terre - Alternariose (Alternaria alternata)_3
Cerise de terre - Alternariose (Alternaria alternata)_3

Citrouille
 Citrouille - Alternariose du fruit (Alternaria alternata)_2
Citrouille - Alternariose du fruit (Alternaria alternata)_2

Concombre
 Concombre - Alternariose (Alternaria alternata)_2
Concombre - Alternariose (Alternaria alternata)_2
 Concombre - Alternariose (Alternaria alternata)_3
Concombre - Alternariose (Alternaria alternata)_3
 Concombre - Alternariose (Alternaria alternata)_4
Concombre - Alternariose (Alternaria alternata)_4
 Concombre - Alternariose (Alternaria alternata)_5
Concombre - Alternariose (Alternaria alternata)_5

Giroflée
 Giroflée - Alternariose (Alternaria alternata)_2
Giroflée - Alternariose (Alternaria alternata)_2
 Giroflée - Alternariose (Alternaria alternata)_3
Giroflée - Alternariose (Alternaria alternata)_3

Haricot

Pomme
 Pomme - Pourriture du cœur (Alternaria alternata)_2
Pomme - Pourriture du cœur (Alternaria alternata)_2
 Pomme - Pourriture du cœur (Alternaria alternata)_3
Pomme - Pourriture du cœur (Alternaria alternata)_3
 Pomme - Pourriture du cœur (Alternaria alternata)_4
Pomme - Pourriture du cœur (Alternaria alternata)_4
 Pomme - Pourriture du cœur (Alternaria alternata)_5
Pomme - Pourriture du cœur (Alternaria alternata)_5

Pomme de terre
 Pomme de terre - Maladies des taches brunes (Alternaria alternata)_2
Pomme de terre - Maladies des taches brunes (Alternaria alternata)_2
 Pomme de terre - Maladies des taches brunes (Alternaria alternata)_3
Pomme de terre - Maladies des taches brunes (Alternaria alternata)_3
 Pomme de terre - Maladies des taches brunes (Alternaria alternata)_4
Pomme de terre - Maladies des taches brunes (Alternaria alternata)_4
 Pomme de terre - Maladies des taches brunes (Alternaria alternata)_5
Pomme de terre - Maladies des taches brunes (Alternaria alternata)_5